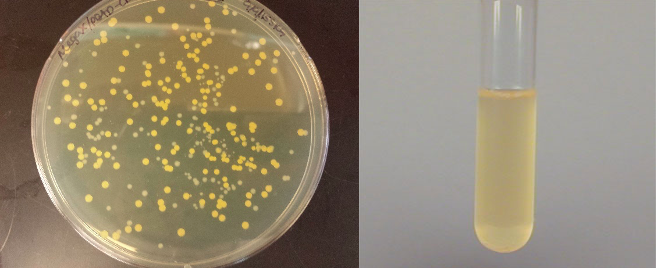

Biyoloji, birçok alt dalı olan temel bir bilimdir. Mikrobiyoloji, biyolojinin bu alt dallarından biridir ve mikroskobik boyuttaki canlıları inceler. Her ne kadar gözümüzle göremediğimiz için yok saysak da gerek yaşamın devamı için gerekse de canlı vücudu için önemli rolleri vardır. Aynı zamanda tehlikeli hastalıkların da sebebi olabilirler. Biyolojinin önemli bir parçası olan mikroorganizmaların evrimini ve yaşamdaki yeri konusunu, bu alanda önemli çalışmaları olan Sayın Georgy Kurakin ile gerçekleştirdiğimiz röportaj sayesinde açıklığa kavuşturmayı hedefliyoruz.
Georgy Kurakin
Röportaj: Beyza Şentürk
Sayın Kurakin, öncelikle röportajımıza zaman ayırdığınız için çok teşekkür ederiz. Dilersenin hemen sorulara geçelim. Mikroorganizmanın ne olduğunu tanımlayabilir misiniz? Ekoloji ve biyoçeşitliliğin devamına katkıları nelerdir?
Ben teşekkür ederim. Temelde mikroorganizmalar, çıplak gözle göremediğiniz yaşayan varlıklardır. Ama bu ifadeyi daha katı ve bilimsel yapmak için; sadece prokaryotlar, tek hücreli ökaryotlar ve virüsler mikroorganizmalar olarak adlandırılır. Eğer genetik ve biyokimyasal perspektiften bakarsak, bu küçük organizmalar, şaşırtıcı şekilde Dünya’nın biyoçeşitliliğinin büyük çoğunluğunu oluşturur. Dahası, bu biyoçeşitliliğin büyük çoğunluğu, prokaryotların — bakteriler ve arkeler — payıdır. Evrimsel açıdan bakacak olursak, her birimiz — hayvanlarla, bitkilerle, mantarlarla ve hatta cıvık mantarlarla birlikte — tamamen bakteriyel endosimbiyontlarla doldurulmuş garip egzotik bir arke grubuyuz. Dışarıda yaşayan tüm canlılar, bakteriler ve arkeler tarafından temsil edilir. Bunların büyük kısmı, kültürlenmemiştir [mikroorganizmaları laboratuvar ortamında çoğaltma yöntemi] ya da mikroskop altında gözlenmemiştir. Onlar hakkında bilgi sahibi olmamızın tek sebebi, genomlarını okuyabilmiş olmamızdır.
Evrimsel açıdan bakacak olursak, her birimiz — hayvanlarla, bitkilerle, mantarlarla ve hatta cıvık mantarlarla birlikte — tamamen bakteriyel endosimbiyontlarla doldurulmuş garip egzotik bir arke grubuyuz.
Bu prokaryotlar, dünyadaki biyokimyasal reaksiyonların büyük çoğunluğunu gerçekleştirir; böylece küresel biyojeokimyasal döngülere güç verirler. Örneğin, azot döngüsü tamamen bakteriler tarafından gerçekleştirilir: azot fiksasyonu, amonyak oksidasyonu, nitrifikasyon ve denitrifikasyon süreçleri sadece bakteriler tarafından gerçekleştirilir. Bunun anlamı, her şeyin yanı sıra, proteinlerinizdeki herhangi bir azot atomunun ortaya çıkması, bitkilerin kök nodüllerinde yaşayan bakteriler sayesindedir. Ve hatta nefes aldığınız oksijen bile siyanobakteriler tarafından sağlanır. Evet, bitkiler de var; fakat hücrelerinde bulunan kloroplastlar — fotosentez yapan organeller — siyanobakterilerden köken almıştır. Onlar, bitki hücrelerinde bulunan bir çeşit siyanobakteridir. Mitokondriyi saymıyorum bile…

Peki mikroorganizmalar nasıl evrimleşti? Mikroorganizmaların evrim sürecinde herhangi bir dönüm noktasından bahsetmek mümkün mü?
Bir önceki soruda dönüm noktalarından bahsetmeye başladım. İlk dönüm noktası, yaşamın kökeninin ta kendisidir — ve bu, bir röportajda konuşulamayacak kadar tartışmalı ve karmaşık bir konudur. Biz sadece, hücresel hayatın oluşumundan kısa bir süre sonra (ya da belki de tamamen aynı evrimsel zamanda?), canlılar dünyasının bakteriler ve arkeler olmak üzere ayrıldığını biliyoruz. İkisi de tek hücreliydi ve yeni habitatlarda yavaşça kolonileşip oraya adapte oldular… Fakat ilginç hiçbir şey gerçekleşmedi. Bu esnada, bazı bakteri grupları, farklı fotosentetik reaksiyonlar kullanarak güneş ışığından enerji elde etmek için evrimleşti. Ama bu reaksiyonlar, hidrojen sülfür gibi bulunması kolay olmayan bazı kimyasallar gerektiriyordu.
Asıl dönüm noktası, 2 milyar yıldan önce, bu antik bakterilerden bir kısmının fotosentez yaparken suyu reaktif olarak kullanmayı icat etmesiyle başladı.
Asıl dönüm noktası, 2 milyar yıldan önce, bu antik bakterilerden bir kısmının fotosentez yaparken suyu reaktif olarak kullanmayı icat etmesiyle başladı. Bakterilerin yaşayabildiği her yerde su bulunur. Miktarı, teknik olarak limitsizdir. Bu, bakterilere seçilimsel bir avantaj sağladı ve hızlı büyümelerini kolaylaştırdı. Ancak kötü olan tek bir şey vardı: atmosferi, aktivitelerinden ortaya çıkan bir yan ürünle doldurdular — oksijen. Bu olay, ‘Büyük Oksidasyon Olayı’ olarak adlandırıldı ve mikrobiyal dünyada gerçek bir devrimdi. Tüm bakteriler ve arkeler bir sorunla karşılaştı: bu gaza adapte olmak ya da onun hala bulunmadığı mekanlarda saklanmak.
Tüm yaşam, aerobik ve anaerobik organizmalar olarak ayrıldı.
Tüm yaşam, aerobik ve anaerobik organizmalar olarak ayrıldı.
Aerobik organizmalar, bu yeni toksik gazı yakıt olarak kullanabilmek için metabolizmalarını yeniden şekillendirdiler. Bir grup egzotik arke ise bunu sıra dışı bir biçimde yaptı. Yaklaşık 1,5 milyar yıl önce, bir arke, bir veya iki bakteri ile sıkı bir simbiyoz oluşturdu. Bu simbiyoz, nihayetinde bizim ökaryot hücre olarak bildiğimiz karmaşık hücreyi oluşturdu. Katılan bakterilerden biri, mitokondriye — hücre için enerji üreten ve oksijenli solunum yapan organel — dönüştü. Bu enerji kaynağı, sırasıyla, hücrelerimizin daha büyük olmasına ve daha fazla fonksiyon kazanmasına imkân sağladı. Sonuç olarak ortaya çıkan karmaşık hücre yapısı, DNA’yı nükleus içinde izole etmeyi ve gen düzenlemesi [hücrelerin gen ürünlerini — RNA veya protein — arttırmasını ya da azaltmasını sağlayan karmaşık ve çeşitli bir mekanizmadır] için karmaşık bir makine geliştirmeyi sağladı.
Böylece mikropların evrimi, dünyamızı şekillendirdi ve dünyamızın tarihi aslında mikropların tarihidir.
Bu, çok hücrelilik için gerekli olan hücre farklılaşmasının temelini attı. Çok hücrelilik, ökaryot nesilde prokaryot nesilden çok daha fazla ortaya çıktı ve daha karmaşık formlara ulaştı — filamentli siyanobakteriler ve miksobakterilerin mantar benzeri meyve veren gövdeleri, en kompleks bakterilerdir; ökaryotlar ise bitkiler ve hayvanlar gibi kompleks formları içerir. Böylece mikropların evrimi, dünyamızı şekillendirdi ve dünyamızın tarihi aslında mikropların tarihidir.
Şimdi, tüm hayatın evrim geçirdiği gibi, mikroplar da evrim geçiriyor. Fakat asıl fark, bu evrimin hızıdır. Mikropların bölünme süresi, hayvanlardan ya da insanlardan çok daha kısadır — bu durum, virüslerin ve bakterilerin aylar veya yıllar içinde tamamen değişmesinin sebebidir. Bu süreç, örneğin, yeni tür virüslerin ortaya çıkmasına ve bakterilerde antimikrobiyal direncin yayılmasına olanak sağlar.

İnsan mikrobiyomunun rolü nedir? İnsanlarla birlikte evrimleşebilirler mi?
Her sene, insan mikrobiyomunun rolü hakkında bir sürü makale yayınlanır. Bunlar genellikle, bazı tıbbi ya da fizyolojik durumlarla insan mikrobiyomu arasında bir ilişki bulmayı amaçlayan genomik, proteomik veya metabolomik çalışmalardır. Ancak ‘-omik’ yöntemler, genellikle takım düzeyindeki araştırmalara olanak tanır. Takım, familyadan daha büyük olan, nispeten geniş bir taksonomik bakteri grubudur. Oysa cins veya tür düzeyindeki biyokimyasal ve sinyalizasyon süreçleri benzersizdir. Kullanılan metodolojiler ile gerçek bilimsel talepler arasındaki bu uyumsuzluk, bilgimizi oldukça eksik kılar.
Dünyayı ziyaret edemediğinizi ve hayvanlarımızı göremediğinizi, ama yıldızlararası bir keşif aracı gönderebildiğinizi, kara hayatından metagenomik [sekanslama adı verilen bir yöntemle genetik materyalin incelenmesidir] örnekler toplayabildiğinizi ve şehir metagenomu ile orman metagenomunu karşılaştırabilen bir uzaylı olduğunuzu hayal edin. Bir şehrin, daha çok primat ve etobur miktarı, daha az ise genel çeşitlilik gösterdiğini göreceksiniz. Primatların, tıpkı etoburlar gibi, bazı ormanlarda da görüldüğünü fark edeceksiniz.
Bu bilgi, insanların şehirde yaşama biçimi ve kültürü hakkında bilgi sahibi olmanıza yardımcı oldu mu? Bu örnekten, kedilerimiz ve köpeklerimizle ilişkimiz hakkında herhangi bir şey anlayabildiniz mi? Eğer sadece bu bilgiye sahip olsaydınız, evcil bir kedi ile bir kaplan arasındaki fark hakkında en ufak bir fikriniz olur muydu?
Bu düşünce deneyinde, kediler ve köpekler bizim etoburlarımızdı ve biz primatlardık. Bizim örneğimizdeki bir uzaylı, farklı biyoloji, yaşam ortamı ve bize karşı farklı tutumları olan iki tür arkadaşımız olduğunu bile bilmeyecekti. İnsan-mikrobiyom sistemi hakkındaki sorunuza geniş bir şekilde cevap verdiğimi sanıyorum.
Mikroorganizmalar çevre kirliliğinde nasıl kullanılabilir?
Mikroorganizmaların çevre kirliliği ile mücadelede kullanılmasının ana fikri, plastik ve petrol gibi kirleticileri ayrıştırmak için onların metabolik becerilerinden faydalanmaktır. Konuşmamızın başında söylediğim gibi, bakteriler, hayvanların ve hatta bitkilerin yapabildiğinden çok daha fazla biyokimyasal reaksiyon gerçekleştirebilir. Ve bu, petrol yiyebilen ve okyanus yüzeyinde bulunan petrolü ayrıştırabilen (bu gibi birçok bakteri var!) ya da plastik yiyen (bu bakterilerden daha az mevcut, fakat bazen keşfediliyorlar) bir bakteri bulmak için gerçek bir şans.
Bakteriler; hayvanların ve hatta bitkilerin yapabildiğinden çok daha fazla biyokimyasal reaksiyon gerçekleştirebilir.
Ama bu bakteriler her şeyin tedavisi değildir. Atmosferden karbondioksiti sabitleyen birçok bakterimiz olduğunu hatırlayın. Dahası, aynı şeyi yapan bitkilerimiz var. Peki, bu bize fazla sera gazını uzaklaştırmamız ve küresel ısınmayı durdurmamız konusunda yardımcı oldu mu? Henüz değil. Dahası, biz bitkilerin gücünü takdir etmiyor ve zararlı sürece yardımı dokunabilecek ormanları yok ediyoruz.Bu durumda plastik yiyen mikropları takdir edecek miyiz? Bir avuç bakteri, sorumlu tüketim ve sürdürülebilir kalkınma olmadan hiçbir şey yapamaz.

İklim değişikliğinin, mikroorganizmaların evrimi üzerinde herhangi bir etkisi var mı?
Evet, maalesef, bazı endişe verici etkiler var. Öncelikle, vahşi hayvanların coğrafi aralıklarını değiştirebilir; böylece yeni zoonotik virüslerin hayvanlardan insanlara yayılmasını sağlar. Covid-19 pandemisi ve ardından SARS-CoV-2’nin popülasyonumuza girişi hepimize bir derstir.
Ama yakın zamanda The Skeptic dergisinde ele aldığım bir tehdit daha var: mantar tehdidi.
Mantarların çoğu psikrofildir. Bunun anlamı, büyümek için daha düşük sıcaklıkları tercih ederler. Buna karşılık, memeliler asteroit çarptıktan ve dinozorları öldürdükten sonra Dünya’da bol miktarda bulunan mantarlara karşı bir bariyere sahip olmak için sürekli yüksek vücut sıcaklığına sahip olacak şekilde evrimleştiler. Bu evrimsel çözümden dolayı, şu ana kadar çoğu mantar bizim için güvenli: onlar için fazla sıcağız.
Memeliler asteroit çarptıktan ve dinozorları öldürdükten sonra Dünya’da bol miktarda bulunan mantarlara karşı bir bariyere sahip olmak için sürekli yüksek vücut sıcaklığına sahip olacak şekilde evrimleştiler.
Ama çevre sıcaklıkları arttıkça, mantarlar buna uyum sağlıyor ve termal optimumunu [optimum sıcaklık noktası] artırıyor. Ve bizim sıcaklık bariyerimiz giderek daralıyor. En kötü senaryoda, tamamen yok olabilir. Eğer bu eğilim artarsa, gelecekte daha fazla mantar patojeninin ortaya çıkmasını bekleyebiliriz.
Yanlış antibiyotik kullanımının mikroorganizmaların evrimi üzerindeki etkisi nedir? Bunun gelecekte patojenlerle mücadele etmemizde bir sorun teşkil edeceğini düşünüyor musunuz?
Antimikrobiyal direnç şu an çok büyük bir problem: çoklu ilaç direncine sahip bakterilerin artan oranı, yakında bazı bakteriyel enfeksiyonları tedavi edecek ilaçlarımızın kalmayacağı gibi üzücü bir olasılığı beraberinde getiriyor.
Ama antimikrobiyal direncin birçok kaynağı var. İlaçların yanı sıra, kullanılan antimikrobiyal ilaçlar, örneğin tarımda da çiftlik hayvanlarını tedavi ve büyümelerini teşvik etmek için kullanılır. Diğer alanlardaki kullanımını kontrol etmeden, insanlarda yanlış kullanımı azaltmak faydasız olacaktır. Antimikrobiyal direnci kontrol etmeye yönelik önlemler kapsamlı olmalıdır.
Ancak, tıbbi öneri olmadan antibiyotik almak gerçekten tehlikelidir. İlk olarak, yanlış tedavi rejiminin vücudunuzdaki dirençli suşların [biyolojik bir türün -genellikle bakteri- bir kültürü, alt türü veya genetik varyantını ifade eder] seçilmesine yol açma riski önemlidir. Her hasta, bakterilerin günler içinde evrimleşebileceğini hatırlamalıdır. Soğuk algınlığından kurtulurken bir süper böceği [süper bakteriyel patojen-birden fazla antibiyotiğe dirençli ve antibiyotikle tedavi edilmesi çok zor olan bakteriler] seçmek çocuk oyuncağı!
Antimikrobiyal direnci kontrol etmeye yönelik önlemler kapsamlı olmalıdır.
Öte yandan, kendi kendini antibiyotikle tedavi etmek, belirtilen tedaviyi geciktirebilir ve bu risk ölümcül olabilir. Örneğin, bir hasta ameliyat gibi başka bir tedaviye ihtiyaç duyarken irinli bir enfeksiyonu dindirmek için kontrolsüz antibiyotik kullanabilir.
Bazı ülkeler eczanelerde reçetesiz herhangi bir antibiyotiğin satılmasını yasakladı. Ama bence hasta eğitimi ve halka erişim daha önemli. Çoğu insanın antibiyotik kullanımın büyük bir sorumluluk olduğunu ve antibiyotik kullanmadan önce tıbbi tavsiye almayı hedeflemenin daha güvenli olduğunu anlamasını sağlamadan, yasaklamalar kısıtlı bir etki gösterir.
Çevre kirliliğinin ve antimikrobiyal direncin ortak bir yönü var: Bunlarla mücadele etmek çevreci bir bakış açısı ve duyarlı tüketim becerileri gerektirir. Aynı zamanda, bilim insanları sınırlı imkanlarını yeni antimikrobiyaller ve biyoremediasyon [çevre kirleticisinin mikroorganizmalar yardımıyla uzaklaştırılması işlemi] bakterileri yaratmak için kullanmalılar. Mikrobiyal dünya ile ilişkimiz zorluklarla dolu. Bu meseleleri ele almak için, bilim ve toplum gayretlerini ve arzularını tek bir amaç doğrultusunda birleştirmeler: her birimiz için daha güvenli bir dünya.
Sayın Kurakin, bu önemli bilgiler için çok teşekkürler . Çalışmalarınızda başarılar dileriz.
Ben teşekkür ederim.
Not: Köşeli parantez içerisindeki notlar editöre aittir.

